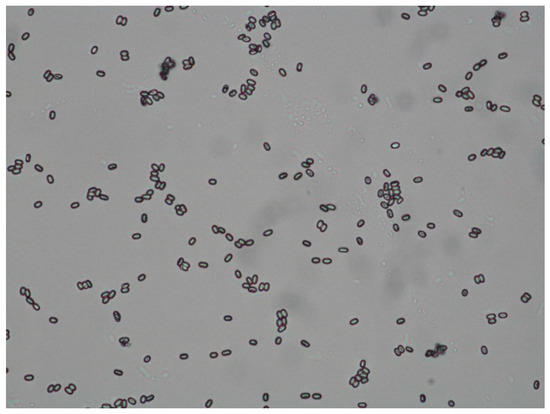

Abstract
Chronic Bee Paralysis Virus (CBPV), a widespread honey bee RNA virus, causes massive worker bee losses, mostly in strong colonies. Two different syndromes, with paralysis, ataxia and flight incapacity on one hand and black hairless individuals with shortened abdomens on the other, can affect a colony simultaneously. This case report presents two Apis mellifera carnica colonies with symptoms of paralysis and hairless black syndrome in 2019. Via RT-PCR, a highly positive result for CBPV was detected in both samples. Further problems, such as a Nosema infection and Varroa infestation, were present in these colonies. Therapy methods were applied to colony 1 comprising queen replacement, shook swarm method and Varroa control, whereas colony 2 was asphyxiated after queen loss and colony weakening. After therapy, colony 1 was wintered without symptoms. Beekeeping and sanitary measures can save a CBPV-infected colony, while further complications result in total colony loss.
1. Introduction
The Western honey bee, Apis mellifera L., the most important pollinator in agriculture worldwide, is managed with the additional aim of honey production. Different pathogens are threatening these honey bee colonies. According to the collaborative German bee monitoring project with around 100 beekeepers involved, the most important diseases are varroosis, nosemosis and various bee viruses [1]. Nosemosis is a disease caused by the microsporidia N. apis and N. ceranae. They are obligate intracellular pathogens causing dysentery and diarrhea after parasitizing and damaging the epithelial cells of the midgut. In spring 2018, the honey bee colonies involved in the German monitoring programme were Nosema-positive in 44% of cases [2].
Varroa, a reddish-brown crab-shaped mite, is one of the most important reasons for winter losses and the main pathogen posing a risk to honey bee colonies. It weakens the bees by feeding from the bee’s fat bodies and harms the brood during their reproduction cycle in the combs [3]. In addition to being harmful itself, Varroa serves as a vector for various bee viruses, e.g., for the Deformed Wing Virus. In 2008, Celle et al. detected 1.4 × 104 copies of Chronic Bee Paralysis Virus in Varroa mites and recognized the possibility of an infection of different hymenoptera like Formica rufa [4]. Varroa, then discussed as being a natural reservoir of CBPV, is rather unlikely as a vector, because there is no proven causal relation between Varroa infestation and CBPV in honey bee colonies. CBPV, the first bee virus ever described and isolated in 1963 [5], is a positive-sense, single-stranded RNA virus that is spread all over the world and mostlyaffects strong colonies with two different syndromes, often simultaneously seen in colonies—paralysis, trembling and crawling bees on one hand and hairless, black bees, with shortened abdomens on the other hand—both ending up in massive worker bee losses. Aristotle has already described the symptoms of the hairless black syndrome and called those bees “thieves” [6]. All casts of bees can be infected by the virus, but there seems to be a kind of behavioral protection for the queen bee [7], which might be the reason that often the queen and some workers remain in an affected colony.
The predominant neurologic symptoms, like the eponymous paralysis and ataxia, are caused by the neurotropism of the virus. Although the head comprises just 1/10 of the whole bee mass, half of the CBPV copies in an infected bee are located there, especially in neurons of the mushroom bodies and central complex, regions where movements are controlled [8]. Diseased bees are attacked by their hive mates, who cut off their hairs with their mandibles and cause the hairless black abdomens [9]. Ingesting the hairs of infected bees is one way of infection. Other possible infection routes are infection through feces or trophallaxis [4].
Almost identical symptoms are produced by Acute Bee Paralysis Virus, but bees die in between one and two days after infection. In contrast, chronically paralyzed bees live for several days in cage experiments [10]. In recent years, Chronic Bee Paralysis seems to be an emerging disease. Budge et al. [11] studied CBPV prevalence in England and Wales between 2007 and 2017. The number of reported cases increased from 1 case in 2007 to 45 cases in 2017 [11]. Other countries see rising numbers of CBPV-positive colonies in their monitoring, e.g., the US with 0.7% in 2010 and 16% in 2014 [12] or Italy with 5% in 2009 to 10% in 2010 [13]. The German bee monitoring also mentioned a notably high prevalence of CBPV in the investigated colonies in 2013 (35.8%) and 2014 (20.7%) [2].
This case report shows the course of two colonies in Germany suffering from an overt CBPV infection in 2019.
2. Case Description
2.1. Medical History, Appearance of the Hive and Environment
Both Apis mellifera carnica colonies are situated in Leipzig (51°20′36.5244″ N, 12°23′15.9792″ E), a city in the Federal Republic of Germany in a region with oceanic climate with continental influence.
Colony 1 was situated next to two polystyrene hives on a 0.5-m-high metal stand in a wooden Zander hive. The hive consisted of one honey super and two brood chambers with ten frames each. It stood in an institute courtyard in an area with many chestnut, robinia and linden trees in the south of the city (Figure 1A). The entrance holes were oriented to the south.

Figure 1.
(A) Apiary 1 with colony 1 in a wooden Zander hive with one brood chamber in March 2020 (orange arrow), ©Julia Dittes. (B) Apiary 2 with colony 2 in a violet painted wooden Zander hive with two brood chambers and one honey super (second in the row) in June 2019 (orange arrow), ©Julia Dittes.
Colony 2 was part of an apiary with six hives at a location a few hundred metres away from apiary 1. The wooden Zander hives stood in pairs on wooden pedestals or metal racks in the south of a small ancillary building with their entrance holes facing south as well. This hive also consisted of a honey super and two brood chambers with ten frames each (Figure 1B).
Both colonies were managed under the principles of good beekeeping practice and had been in a healthy status during the previous season.
Varroa infestation in both colonies was controlled by a combination of biotechnical methods and miticides. On 8 April 2019, the first frames without foundation and wire were put into the colonies for building drone combs. During the weekly health checks, drone brood was removed from the hive regularly and the building frames put back into the colony.
2.2. Examination of the Alighting Board and Observation of the Entrance Hole
Observation of the entrance holes of both colonies in the beginning of May 2019 showed some isolated bees flying. Compared to the other hives at the apiaries, colony activity was significantly lower. Some dead bees lay on the alighting boards and a large quantity of dead bees was found in front of the hives (Figure 2A), which produced a certain putrid smell. Between those dead bees, some flightless crawling ones were spotted.

Figure 2.
(A) Dead bees laying on the stone floor tiles and grass in front of the hive of colony 2 (orange circle), ©Julia Dittes. (B) Close-up of scattered brown feces found on the hive of colony 1 (orange arrows), ©Julia Dittes.
At the front of the first colony’s hive, additionally some scattered dark brown feces were visible (Figure 2B).
2.3. Clinical Examination of the Honey Bee Colonies and Observation of Living Bees
Clinical examination of colony 1 showed an empty honey super with undeveloped wax foundations and many bees with hairless, dark and shortened abdomens as well as some bees looking like ants in the brood chambers (Figure 3). The affected bees were trembling, atactic, with slow or no reaction when exposed to smoke, and held their wings at an unusual angle. Their movements were abnormal and erratic. Workers as well as drones showed clinical signs of paralysis (Supplementary Materials Videos S1 and S2). The nest consisted of five frames, one of them with drone brood, four with worker cells, and two regular drone brood frames. A large number of drones was seen in the colony.

Figure 3.
Clinical examination of colony 1: worker bee with hairless, “black” abdomen (blue arrow); worker bee with ant-like phenotype (orange arrow), ©Julia Dittes.
The same clinical findings were observed in colony 2, with a brood nest out of six frames and two drone brood frames in the upper brood chamber. According to the Liebefeld method [14,15], with more than 7000 bees estimated, both colonies had nearly the same number of worker bees in the upper brood chamber, whereas the number of brood cells differed (approximately 14,200 in colony 2; 15,400 worker bee cells in colony 1).
In contrast to colony 1, colony 2 started storing honey (approximately 4.1 kg) in the honey super. During the course of the disease, the dead queen of colony 2 was found in front of the hive on 10 May 2019. Later on, worker bees started laying eggs into the cells of colony 2 (Figure 4).

Figure 4.
Close-ups of a drone brood comb of colony 2 with more than one egg or larvae per cell, ©Julia Dittes.
From these unfertilized eggs, only drones developed, and the colony weakened progressively.
Examination of Dead Bees
Samples of dead bees were examined using the methods described in Dittes et al., 2020 [16]. The bees of both colonies showed the same symptoms as previously seen in the colony: Some bees were about 3 to 4 mm smaller than common, most of the bees had an extended proboscis. The abdomens were hairless, black, greasy shining, shortened and in some individuals bloated. Under pressure on the abdomen a light brown fluid leaked from the gut.
The queen of colony 2, showed the same problems, as well as drones of both colonies, so that all casts of bees were affected by the disease.
2.4. Laboratory Diagnosis
2.4.1. PCR-Diagnosis of CBPV and Further Viruses
RT-PCR was performed for both colonies at the end of May 2019 at the Federal Research Institute for Animal Health (FLI, Greifswald–Isle of Riems). After homogenizing ten bees from each sample with the gentleMACSTM Dissociator, total RNA was purified from 150 µL of clarified bee homogenate using the RNeasy Mini Kit (Qiagen, Venlo, NL, USA). A one-step real-time RT-PCR was subsequently performed in duplicate using the AgPathIDTM One-Step RT-PCR Kit (Applied BiosystemsTM, Waltham, MA, USA) in a 96-well reaction plate [17]. Detailed information of the methods used can be found in Dittes et al., 2020 [16]. The results are expressed as the mean of the two replicates for each reaction.
Both samples were positive for CBPV showing a threshold cycle (Ct) below 20 for each amplification. Furthermore, titres of Deformed Wing Virus (DWV) and Black Queen Cell Virus (BQCV) were detected in the samples of both colonies without causing clinical findings. Acute Bee Paralysis Virus (ABPV) was not or barely detected (Table 1).

Table 1.
Virus titres detected in two honey bee colonies in May 2019.
2.4.2. Diagnostics of Further Diseases
Monitoring the Varroa Infestation
There are different methods to estimate the mite load [16]. The number of mites in this case was estimated from the natural mite fall, the number of mites per day falling naturally from the bees down to the bottom board. An oil-coated paper towel was placed on a drawer under the wire-mesh floor for 2 to 3 days and the mites, naturally fallen from the bees to the floor, were counted in the debris. Female Varroa mites are from 1.2 to 1.7 mm, crab-shaped and reddish brown and can be seen with the naked eye [18]. In Table 2, the control plan and the natural mite fall with a merely low infestation rate are shown for colony 1.

Table 2.
Varroa screening plan in 2019 by debris examination for the surviving colony 1.
Detection of Nosemosis
A microscopic estimation of the number of spores was carried out using the scheme described by Ritter in 1996 [19]. Colony 1 had a moderate infestation (between 20 and 100 spores per visual field), Colony 2 was only slightly affected (less than 20 spores per visual field) (Figure 5). For further differentiation of the species N. apis and N. ceranae, a PCR would be required, but was not performed in this case.
Figure 5.
Microscopic image of oval-shaped Nosema-spores. (unstained, 400x) Differentiation of the species is not possible under the microscope. ©Heike Aupperle-Lellbach.
2.5. List of Medical Issues and Diagnoses
Table 3 lists the main problems of the colonies. In sum, an overt infection with Chronic Bee Paralysis Virus was diagnosed in both colonies. In addition, a co-infection with Nosema was proven with different infestation grades in the colonies.

Table 3.
List of medical issues in two honey bee colonies infected with Chronic Bee Paralysis Virus (CBPV) in 2019.
Treatment methods were only applied to colony 1. After queen loss, a surplus of drones and laying worker bees, the prognosis was too bad for colony 2.
2.6. Therapeutic Measures and Outcome
Due to the bad prognosis, colony 2 was asphyxiated with sulphur on 17 June 2019.
For therapy of colony 1, measures such as re-queening, shook swarm method and Varroa infestation control were applied. Further information on those methods can be found in Dittes et al. 2020 [16]. Table 4 summarizes the therapeutic measures and further development of colony 1.

Table 4.
Therapeutic measures and outcome of colony 1 after diagnosis of an overt CBPV infection.
No symptoms of paralysis were shown by the bees during the weekly check-ups in 2020 (Video S3). CBPV was not detected via RT-PCR any longer. The vital colony (Figure 6) started honey production in the following weeks. In total, about 36 kg of honey was harvested from colony 1 in 2020 in an apiary averaging 42 kg of honey per colony.

Figure 6.
Development of the rehabilitated colony 1 after wintering/hibernation on 28 April 2020 during apple blossom (brood on 9 combs [Zander 477 × 220 mm], honey super empty), F19: capped drone brood, F20 + F7: brood-comb with eggs, F18 + F6: brood-comb with mostly covered worker brood, F12: build up drone brood frame ©Ilka Emmerich.
3. Discussion
Paralysis of honey bees was systematically studied for the first time by Burnside [20] nearly 100 years ago in 1933. Performing many cage experiments spraying, injecting and feeding healthy bees with extract from sick bees, he observed bees attacking their hive mates [20]. After further infection experiments in 1945, Burnside drew the conclusion that a filtrable virus is the cause of the disease [21]. However, it took another 20 years until Bailey first isolated Chronic Bee Paralysis Virus [5], a virus that causes neurologic symptoms. Clinical findings are trembling, crawling, circling bees and flightless bees without orientation, because the virus affects neurons of higher-order integration centres, optic and antennal lobes, which are involved in locomotion control, learning and orientation behavior [18]. At the same time, phenotype changes in bees are seen: black hairless shiny abdomens and smaller bees with shortened abdomens. In the beginning, CBPV was characterized by two distinct syndromes, the paralysis form and the hairless black syndrome, but both can occur in colonies at the same time, as was observed in the two described ones. All symptoms may lead to a high mortality within a few days, with massive worker bee losses.
Acute Bee Paralysis Virus, which produces the same symptoms but leads to a faster death of affected bees, could be excluded through differential diagnosis via PCR, where it was not or just marginally detected.
In formerly strong colonies just the queen and a few workers remain. Amiri et al. [7] compared the queen’s and the worker bee’s susceptibility. Infection experiments for both workers and queens resulted in the same symptoms after 6 days and a 100% mortality after 14 days. There seem to be behavioral strategies to protect the queen, e.g., only healthy bees feeding her [7]. The observations in this case confirm that for colony 1. The queen of colony 2 died and was found in front of the hive. However, it is not possible to clearly determine the cause of the queen’s death. She could have been affected by CBPV, too, but she also could have been harmed while handling the colony or was to be replaced by a new queen, because of failures detected by the workers. Replacement by supersedure, which is done with old queens, can be nearly ruled out, because it was a young queen raised in 2018, one year prior. Normally, the colony would have reared a new queen. However, instead, laying worker bees started ovipositure in a disordered way in the absence of the queen’s pheromones. From these unfertilized eggs, only drones developed, and with a declining number of working honey bees, the colony weakened and could not be rehabilitated. Asphyxiating with sulfur is the standard method to end a colony’s life, as was done to colony 2.
CBPV often persists as a covert infection in honey bee colonies, detectable via PCR, without causing obvious symptoms, clinical findings and problems within the colony. Different factors favour the change into an overt infection. The interaction between these factors is not understood in detail yet, but periods of bad weather or a lack of nectar and starving are discussed. Taking a look at the weather in May 2019 in Germany, the temperatures were about 1.2 °C colder than normal, especially during the first half [22]. Cold and rainy conditions outside make the bees stay in the hive, intensifying their direct contact and may facilitate the spread of the virus. Direct contact plays a predominant role in transmission during disease outbreak [8].
Infected bees suffer from nibbling attacks of their hive mates, cutting their hairs off. This leads to the black hairless shiny abdomens of the attacked ones and the ingestion of bee hairs by the attackers. Rinderer et al. investigated the effect of hairs removed from the bodies of infected honey bees in infection experiments and saw that bees fed with virus and infected hairs showed a significantly higher mortality than bees fed only with one of both [9].
A high density of bees in the hive also increases the amount of and the contact with feces, another possible way of transmission. The virus load in bee excreta is as high as in the heads of symptomatic bees (1010 CBPV RNA copies) [23]. In the described colonies a co-infection with Nosema was detected. These microsporidia cause dysentery and diarrhea through damage of the midgut epithelial cells, which results in more feces in the hive, especially under the weather conditions described above. Toplak et al. investigated the effect of a co-infection of CBPV and Nosema ceranae in bees under experimental conditions. Bees infected with Nosema showed an increased replication ability for CBPV [24]. The damage to the midgut epithelial cells and a suppression of the immune response of the honey bees increase the virulence of the viral pathogens. The co-infection may have had a synergistic effect on the CBPV outbreak in the described cases. While the species were not differentiated via PCR, according to the German bee monitoring, the dominant species was Nosema ceranae in more than 96% of the Nosema-positive samples in 2018 [1,2], so it is the most likely species here as well.
Furthermore, the Varroa mite was discussed to be a vector and natural reservoir for CBPV. Investigations into mites showed a titre of 1.4 × 104 particles per mite, which is quite low. However, minus strand RNA was detected, which is indicative of virus replication. Varroa was and is present in the described colonies and also acts as a general weakening factor for honey bee colonies, therefore an intense Varroa infestation control has to be done.
There are no specific drugs or therapy measures against viral diseases, so a therapy has to rely on sanitary measures and basics of good bee keeping. Bailey described in 1965 that re-queening was a helpful measure in naturally CBPV-infected colonies [5]. In surviving colony 1, re-queening was the first step to rehabilitation, followed by the shook swarm method. Artificial swarming is often used to decrease the load of a pathogen in the bee hive, e.g., of American foulbrood. The bees got a new hive with new and clean combs. In the same step, a brood-less period was induced, allowing for a Varroa treatment by spraying oxalic acid. With the combination of these measures, a total recovery of colony 1 was possible. In colony 2, the intervention came too late to save it.
4. Conclusions
If diagnosed in time, an overt CBPV infection can be treated successfully with bee keeping and sanitary measures. There is a good prognosis for the affected colony. In case of further complications, the infection can result in a total colony loss. A survey about therapy measures and outcome among beekeepers with confirmed CBPV-positive bee colonies during recent years should gather information on successful strategies to be applied to affected colonies in the future.
It remains to be seen how CBPV will spread in the next years, and whether Germany will experience a similar growth to England and Wales. Furthermore, research about the specific factors that lead to an outbreak is required in order to develop strategies for preventing overt infections in colonies.
Supplementary Materials
The following are available online at https://www.mdpi.com/2306-7381/7/3/142/s1, Video S1: trembling and ataxia, hairless, black bees in colony 1_May 2019; Video S2: trembling_paralysis_hairless black bees in colony 2_May 2019; Video S3: normal behaviour of colony 1 in May 2020.
Author Contributions
Conceptualization, C.K.W.M., H.A.-L. and I.U.E.; methodology, J.D., I.U.E., M.O.S.; validation, J.D., I.U.E.; formal analysis, J.D.; investigation, J.D., I.U.E. and M.O.S.; resources, C.K.W.M.; writing—original draft preparation, J.D.; writing—review and editing, I.U.E., H.A.-L.; visualization, J.D., I.U.E.; supervision, C.K.W.M., I.U.E., H.A.-L.; project administration, C.K.W.M. All authors have read and agreed to the published version of the manuscript.
Funding
This research received no external funding.
Conflicts of Interest
The authors declare no conflict of interest, although H.A.-L. and M.O.S. are working in laboratories, that regularly offer the laboratory diagnostics. The company (LABOKLIN GmbH & CO.KG) had no role in the design, execution, interpretation, or writing of the study.
References
- Genersch, E.; von der Ohe, W.; Kaatz, H.; Schroeder, A.; Otten, C.; Büchler, R.; Berg, S.; Ritter, W.; Mühlen, W.; Gisder, S.; et al. The German bee monitoring project: A long term study to understand periodically high winter losses of honey bee colonies. Apidologie 2010, 41, 332–352. [Google Scholar] [CrossRef]
- Rosenkranz, P.; von der Ohe, W.; Schäfer, M.; Genersch, E.; Büchler, R.; Berg, S.; Otten, C. Zwischenbericht 2018 Deutsches Bienenmonitoring–DeBiMo Projektlaufzeit 1.1.2017–31.12.2019, Berichtszeitraum 1.1.2018–31.12.2018. Available online: https://bienenmonitoring.uni-hohenheim.de/88584?tx_ttnews%5Btt_news%5D=44864&cHash=b943160d769aa565de89b191d468bd9e (accessed on 11 June 2020).
- Ramsey, S.D.; Ochoa, R.; Bauchan, G.; Gulbronson, C.; Mowery, J.D.; Cohen, A.; Lim, D.; Joklik, J.; Cicero, J.M.; Ellis, J.D.; et al. Varroa destructor feeds primarily on honey bee fat body tissue and not hemolymph. Proc. Natl. Acad. Sci. USA 2019, 116, 1792–1801. [Google Scholar] [CrossRef] [PubMed]
- Celle, O.; Blanchard, P.; Olivier, V.; Schurr, F.; Cougoule, N.; Faucon, J.-P.; Ribiere, M. Detection of Chronic bee paralysis virus (CBPV) genome and its replicative RNA form in various hosts and possible ways of spread. Virus Res. 2008, 133, 280–294. [Google Scholar] [CrossRef] [PubMed]
- Bailey, L.; Gibbs, A.J.; Woods, R.D. Two viruses from adult honey bees (Apis mellifera Linnaeus). Virology 1963, 21, 390–395. [Google Scholar] [CrossRef]
- Aristotle. Aristotle´s History of Animals in Ten Books; Cresswell, R., Translator; George Bell & Sons: London, UK, 1902; pp. 262–263. [Google Scholar]
- Amiri, E.; Meixner, M.; Büchler, R.; Kryger, P. Chronic bee paralysis virus in honeybee queens: Evaluating susceptibility and infection routes. Viruses 2014, 6, 1188–1201. [Google Scholar] [CrossRef] [PubMed]
- Ribière, M.; Olivier, V.; Blanchard, P. Chronic bee paralysis: A disease and a virus like no other? J. Invertebr. Pathol. 2010, 103, 120–131. [Google Scholar] [CrossRef] [PubMed]
- Rinderer, T.E.; Rothenbuhler, W.C. The fate and effects of hairs removed from honeybees with hairless-black syndrome. J. Invertebr. Pathol. 1975, 26, 305–308. [Google Scholar] [CrossRef]
- Bailey, L. Paralysis of the honey bee, Apis mellifera Linnaeus. J. Invertebr. Pathol. 1965, 7, 132–140. [Google Scholar] [CrossRef]
- Budge, G.E.; Simcock, N.K.; Holder, P.J.; Shirley, M.D.F.; Brown, M.A.; Van Weymars, P.S.M.; Evans, D.J.; Rushton, S.P. Chronic bee paralysis as a serious emerging threat to honey bees. Nat. Commun. 2020, 11, 2164. [Google Scholar] [CrossRef] [PubMed]
- Traynor, K.S.; Rennich, K.; Forsgren, E.; Rose, R.; Pettis, J.; Kunkel, G.; Madella, S.; Evans, J.; Lopez, D.; van Engelsdorp, D. Multiyear survey targeting disease incidence in US honey bees. Apidologie 2016, 47, 325–347. [Google Scholar] [CrossRef]
- Porrini, C.; Mutinelli, F.; Bortolotti, L.; Granato, A.; Laurenson, L.; Roberts, K.; Gallina, A.; Silvester, N.; Medrzycki, P.; Renzi, T.; et al. The status of honey bee health in italy: Results from the nationwide bee monitoring network. PLoS ONE 2016, 11, e0155411. [Google Scholar] [CrossRef] [PubMed]
- Imdorf, A.; Buehlmann, G.; Gerig, L.; Klichenmann, V.; Wille, H. Überprüfung der schätzmethode zur ermitllung der brutfläche und der anzahl arbeiterinnen in freifliegenden bienenvölkern. Apidologie 1987, 18, 137–146. [Google Scholar] [CrossRef]
- Deutsches Bienenjournal: Bienenvolk Schätzen: Volksstärken Genau Erfassen (20 Oktober 2016). Available online: https://www.bienenjournal.de/imkerpraxis/ratgeber/volksstaerken-erfassen-quiz/ (accessed on 24 May 2020).
- Dittes, J.; Schäfer, M.O.; Aupperle-Lellbach, H.; Mülling, C.K.W.; Emmerich, I.U. Veterinary diagnostic approach of common virus diseases in adult honey bees. Vet. Sci. 2020, in press. [Google Scholar]
- Blanchard, P.; Ribière, M.; Celle, O.; Lallemand, P.; Schurr, F.; Olivier, V.; Iscache, A.L.; Faucon, J.P. Evaluation of a real-time two-step RT-PCR assay for quantitation of Chronic bee paralysis virus (CBPV) genome in experimentally-infected bee tissues and in life stages of a symptomatic colony. J. Virol. Methods 2007, 141, 7–13. [Google Scholar] [CrossRef] [PubMed]
- Vidal-Naquet, N. Honeybee Veterinary Medicine: Apis mellifera L., 1st ed.; 5m Books Ltd.: Sheffield, UK, 2015; pp. 71–75. [Google Scholar]
- Ritter, W. Diagnostik und Bekämpfung der Bienenkrankheiten, 1st ed.; Gustav Fischer Verlag: Jena, Germany, 1996; p. 51. [Google Scholar]
- Burnside, C.E. Preliminary Observations on “Paralysis” of Honeybees. J. Econ. Entomol. 1933, 26, 162–168. [Google Scholar] [CrossRef]
- Burnside, C.E. The cause of paralysis of bees. Am. BeeJ. 1945, 85, 354–355. [Google Scholar]
- Deutschlandwetter im Mai 2019. Available online: https://www.dwd.de/DE/presse/pressemitteilungen/DE/2019/20190529_deutschlandwetter_mai_news.hthtm (accessed on 29 May 2019).
- Ribière, M.; Lallemand, P.; Iscache, A.-L.; Schurr, F.; Celle, O.; Blanchard, P.; Olivier, V.; Faucon, J.P. Spread of infectious chronic bee paralysis virus by honeybee (Apis mellifera L.) feces. Appl. Environ. Microbiol. 2007, 73, 771–776. [Google Scholar] [CrossRef] [PubMed]
- Toplak, I.; Ciglenečki, U.J.; Aronstein, K.; Gregorc, A. Chronic bee paralysis virus and nosema ceranae experimental co-infection of winter honey bee workers. Viruses 2013, 5, 2282–2297. [Google Scholar] [CrossRef] [PubMed]
© 2020 by the authors. Licensee MDPI, Basel, Switzerland. This article is an open access article distributed under the terms and conditions of the Creative Commons Attribution (CC BY) license (http://creativecommons.org/licenses/by/4.0/).






